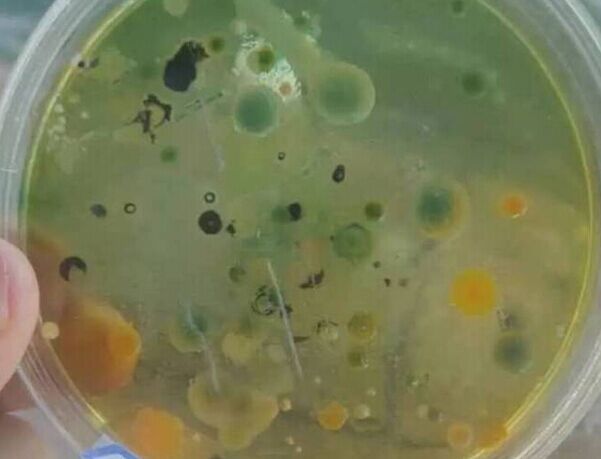

中壓燈紫外線殺菌器以水質調控病害預防為切入點解決南美白對蝦病害問題-下篇
 2017年07月26日 |
2017年07月26日 | 閱讀次數:6645
閱讀次數:6645 對蝦養殖已成為漁業經濟重要的支柱產業之一。是沿海地區脫貧致富的好門路,但是在20世紀80年代后期全球性蝦病大暴發流行,使對蝦養殖遭到毀滅性打擊。實踐證明,新型的養殖模式可增強對蝦營養,提高對蝦免疫和抗病力,有效控制病原密度、減少環境脅迫等可預防病毒病的發生。其中,養殖病害和養殖環境等方面尤為突出,嚴重威脅著對蝦養殖的持續發展。
傳統的消毒殺菌方式如生石灰、漂白粉、強氯精、碘制劑、高錳酸鉀、沸石粉、白云石粉等有諸多的缺點和弊端,人工成本高,費時費力,沛德水處理公司研發生產的南美白對蝦專用中壓燈紫外線殺菌器將這些問題迎刃而解,一經安裝調試投入運行后,無需人工,一勞永逸,中壓燈紫外線殺菌器使用時長,殺菌能力強,無二次污染,節省人工成本,無需排掉大部分塘水、無需測量蝦池中水的體積、無需計算蝦池的總用藥量等等,安裝方便靈活,解決養殖病害、養殖環境等問題,本文接中壓燈紫外線殺菌器以水質調控病害預防為切入點解決南美白對蝦病害問題-上篇文章,針對中壓燈紫外線殺菌器能殺滅的病毒性疾病、細菌性疾病、真菌性和寄生蟲疾病、理化因子引起的疾病以及傳統消毒方式和中壓燈紫外線殺菌器優缺點對比、中壓紫外線燈管與傳統紫外線燈管的對比、養殖病害的分類、南美白對蝦養殖用中壓燈紫外線殺菌器的特點、優勢進行詳細介紹并附上配套工藝圖、安裝示意圖等。細菌性疾病的防治、弧菌病、爛眼病、黑鰓或爛鰓、腸炎病、絲狀細菌病也會進行著重介紹。
南美白對蝦養殖用中壓燈紫外線殺菌器圖片


傳統消毒方式和中壓燈紫外線殺菌器優缺點對比
傳統消毒方式 | 中壓燈紫外線殺菌器 |
藥物有兩面性,使用方法得當,可以防病、治病;使用不當,濫用藥物,可危及食品安全和污染環境;使用在蝦體內長期殘留的治療和消毒藥物; | 無污染環境,無藥物殘留,食品安全得到保障; |
藥效不清楚、藥物成分不分明、是否有主管部門備案批文; | 中壓紫外消毒效果明顯確切; |
放苗前的清塘及水體消毒,要算好藥量和消毒時間; | 傻瓜式使用,任何人可立刻上手; |
水體消毒要等藥性失效后才能肥水放苗; | 可隨時使用; |
養殖期間的水體消毒,需要合理掌握藥效濃度,毒性不能太強,要按養殖的不同對象和個體大小確定用量; | 只要把中壓燈紫外線殺菌器開啟運行即可,不需要計算調整; |
藥物失效時間為2-5天左右; | 流過即消毒,無持續消毒能力; |
高錳酸鉀對蝦類有中度毒性,不能應用于養殖期間的水體消毒,只用于殺滅纖毛蟲。使用時還要排掉大部分塘水,4小時候又要把水進滿; | 中壓燈紫外線殺菌器消毒對蝦安全無毒,對高錳酸鉀難以殺滅的纖毛蟲殺滅效果好; |
使用芽孢桿菌不能與消毒劑或抗生素混合使用; | 通過紫外消毒后,再使用芽孢桿菌不會對芽孢桿菌的生長繁殖造成影響; |
蝦病防治中供選擇的藥物種類繁多,需要對癥下藥才能收到效果。在選擇蝦病治療藥物時,還要區分蝦病的類型;要考慮藥物的理化性質、用量、給藥方法及藥物在體內的代謝等; | 中壓燈紫外線殺菌器廣譜殺菌,不需要選用多種化學藥劑; |
藥物受蝦類的體質、種群、結構等的變化影響到很大,表現出不同的藥物反應;個體大小及養殖密度也會影響用藥效果; | 中壓燈紫外線殺菌器的使用無需考慮蝦類的體質、種群、結構、體大小及養殖密度等因素; |
池塘的PH、溫度、鹽度、溶解氧等對藥物會產生不同的反應與影響,用藥時必須注意水質、季節、氣溫等外界環境的變化; | 中壓燈紫外線殺菌器的使用無需考慮池塘的PH、溫度、鹽度、溶解氧、水質、季節、氣溫等外界環境的變化等因素; |
給藥方法是否恰當,直接影響治療效果; | 傻瓜式使用,殺菌效果好; |
采用全池撒潑藥物時,還要測量蝦池中水的體積,然后按照藥物所需劑量和水的體積計算出蝦池的總用藥量; | 使用中壓燈紫外線殺菌器無需測量蝦池中水的體積、無需按照藥物所需劑量和水的體積計算出蝦池的總用藥量; |
無論用什么藥劑,對養殖水質的影響必須控制在水質標準變化幅度允許范圍之內; | 對水體無二次污染; |
中壓紫外線燈管與傳統紫外線燈管的對比
中壓燈紫外線燈管 | 低壓燈紫外線燈管 |
燈管內氣壓104-106pa 功率高達12000W | 燈管內氣壓<103pa |
南美白對蝦養殖用中壓燈紫外線殺菌器可解決以下病害
病毒性疾病
白斑綜合癥病毒(WSSV)
桃拉病毒病(TSV)
細菌性疾病
弧菌病
爛眼病
黑鰓或爛鰓
腸炎病
絲狀細菌病
真菌性和寄生蟲疾病
對蝦卵及幼體的真菌病
鐮刀菌病
理化因子引起的疾病
黑鰓病
本節內容詳細介紹二大類:細菌性病毒的相關信息。
1.弧菌病
亦稱紅腿病、敗血病
[病因] 該病病原是氣單胞菌屬、副溶血弧菌、鰻弧菌及假單胞菌屬中的一些種類。
[流行及危害] 對蝦感染該病后2~4小時即開始死亡,死亡率可高達90%。發病季節一般在7~10月,華南地區7月下旬至10月中、下旬是該病的高發季節。第三茬養殖的蝦感染率和發病率均很高,該病是南美白對蝦養殖中危害較嚴重的細菌性疾病。弧菌超標能引起對蝦空腸胃、白便、偷死等重大病害,其危害不言而喻。但弧菌是條件致病菌,并不是出現弧菌就會爆發疾病,還與弧菌種類和數量、環境條件、弧菌占總菌比例有關系。
爛眼病

又稱瞎眼病、眼球壞死癥。
(1)病原:革蘭氏染色陰性弧狀短桿菌,無芽孢,極端單鞭毛。
(2)流行與危害:見于南美白對蝦等海蝦。此病多流行于高溫低鹽度的養蝦場內,能引起散發性死亡。
(3)癥狀:病蝦行動呆滯,匍匐于水草上、池邊水底,時而浮起在水面旋轉翻滾。眼球受損、腫脹,角膜的顏色由黑變棕褐色,而后以至潰爛。大多在1周內死亡。
3.黑鰓或爛鰓

黑鰓病 爛鰓病
(1)病原:弧菌或其他細菌。
(2)癥狀:病蝦鰓絲腫脹,呈灰色或黑色,變脆,從鰓絲邊 緣向基部逐漸壞死糜爛,呼吸困難,食欲減退,嚴重時伏于池 邊死亡。養殖池的底質中有機物過剩時容易發生此病。
(3)原因
①中毒性黑變:養殖水體受到化學物質的污染,特別是重金屬離子,如銅、鎘、汞、錳等,氨氮、亞硝酸鹽濃度過高,pH值長期偏低,慢性中毒引起黑變。
②藥物性黑變:由于使用藥物不當造成,如高錳酸鉀、硫酸銅用量過大,藥物粘附于南美白對蝦鰓絲表面,損傷鰓絲,引起黑變。
③營養性黑變:飼料中缺乏維生素C或維生素C含量不足,引起鰓絲黑變。這種情況比較常見。
④環境性黑變:細菌、真菌(如弧菌、絲狀菌)感染。水質、底質惡化,亞硝酸鹽含量過高養殖水體淤泥、有機碎屑、殘留飼料、糞便等有機污染物含量過高,粘附于對蝦鰓絲,常伴有固著類纖毛蟲,引起黑變。
⑤應激性黑變:遇暴風雨或連續陰雨天,惡劣天氣,溶氧、溫度、鹽度分層,引起強烈應激反應,蝦免疫力下降也會引起黑變。
4.腸炎病

急性腸炎導致的消化道發紅腸炎

細菌性腸炎導致的腸道發紅
病因:由嗜水氣單胞菌感染引起,或是因為對蝦吃了藍藻類顫藻科的鈣化裂須藻或螺旋藻后中毒引起的。
病癥:對蝦的腸炎表現為消化道變紅色,胃部較明顯,中腸后部也變紅或腫脹,直腸(后腸)變混濁;同時腸壁紅色素細胞擴張,有大量血細胞聚集;病蝦不活潑、厭食、生長緩慢等。消化道變紅、腫脹和混濁等癥狀從體外就可看清,解剖病蝦,取出消化道,從胃、中腸和直腸剪開各取一小段,將腸壁用壓片法,在高倍鏡下檢查血細胞聚集和紅色素細胞擴張的情形。
6.絲狀細菌病

病原:絲狀細菌中常見的有發狀白絲菌,另外還有發硫菌。發狀白絲菌是革蘭氏陰性菌,需氧,適生長溫度為25℃左右,能忍受的較高溫度30℃~35℃,溫度0℃只能生存1周~2周,此菌必須在有氯化鈉的水中才能生長。
癥狀:絲狀細菌在幼體的體表各處,一端附著,一端游離,它僅以宿主作為生活的基地,用粘液樣物質,附著在宿主體表,并不侵入體內組織,不會從蝦體上吸取營養成分,也未發現宿主組織對絲狀細菌的附著有明顯的反應。因此,它不屬于寄生物,應屬于體表附著物或外共棲生物。但是有人認為發狀白絲菌內有1種內毒素,屬于類脂多糖類,可能對于蝦體有害毒作用。附著在鰓上對對蝦的危害性非常大,且往往附生的數量很多,成絲的菌叢布滿鰓絲表面,菌絲之間還往往粘附物許多原生動物、單細胞藻、有機碎屑或其他污物。這些菌絲和粘附著阻礙了水在鰓絲間的流通,隔絕了鰓絲表面與水的接觸,妨礙了呼吸,增加了對蝦負擔,造成蝦呼吸、蛻殼困難,引起死亡。
南美白對蝦養殖用中壓燈紫外線殺菌器常用配套處理工藝

南美白對蝦養殖用中壓燈紫外線殺菌器安裝示意圖

紫外線殺菌器榮獲歐盟CE認證

南美白對蝦養殖用中壓燈紫外線殺菌器特點
1.單只燈管高功率(400w-10000w/單只),紫外線燈管安裝數量少,可以節省日常維護費用;
2.全不銹鋼外殼防腐蝕,使用時長;
3.紫外線殺菌屬于物理方法,不會對水體和周圍環境產生二次污染;
4.紫外線輸出功率高,殺菌能力強;
5.石英套管透光率高,能量損失小;
6.南美白對蝦養殖用中壓燈紫外線殺菌器體積小,外形美觀,安裝方便靈活。
南美白對蝦養殖用中壓燈紫外線殺菌器優勢
性能優勢
無化學污染,綠色環保
單臺設備可安裝2-18根中壓燈管
中壓燈管的功率分別有2.5千瓦,3.5千瓦,5.0千瓦和7.3千瓦UV燈等
處理水流量可以高達5,000立方米/小時
5000小時燈管時長,石英套管的時長為5年
自動調整100%-50%的紫外輸出功率
優化的低水頭損失設計
操作優勢
顯著減少維護需求
單面維修
全自動機械清洗機構
當需要更換燈管時,無需拆卸清洗盤及電機
安裝優勢
超緊湊,易于安裝
封閉系統的設計直接安裝到管道上
可水平和垂直安裝
多尺寸類型的法蘭,可供安裝配對
顯著減少現場安裝占地面積要求
可直接靠墻安裝
以上列舉的所有細菌性病毒,以及上篇文章提到的所有病毒性疾病、真菌性和寄生蟲疾病、理化因子引起的疾病沛德水處理公司生產的中壓燈紫外線殺菌器都可以解決。較傳統消毒方式有顯著優勢,能夠大大的提高南美白對蝦的抗病力和存活率.
對蝦養殖具有產量高、周期短、見效快和經濟效益顯著的優點,在經濟飛速發展的今天,利用蝦類養殖來創造財富,越來越受到人們的關注和歡迎,掌握蝦類的生活習性及養殖特點,是養殖成功的關鍵所在.光放養、水質好、環境好等一些先天條件,還是不夠的,養殖戶可以根據南美白對蝦的病害征兆及引發病害原因控制好南美白對蝦健康生長。







查看更多(共0條)評論列表